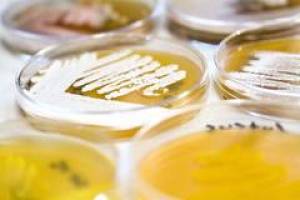
Erbinformation von Bakterien erm�glicht neue Arzneistoffe

wire - kurze nachrichten
Eberhard Karls Universität Tübingen
Ergebnisse 1251 - 1300 von 1421.
Biowissenschaften - 18.05.2011
Immunologie-Gastprofessor aus Japan ernannt
Neue Kooperation der Universität Tübingen mit der RIKEN-Wissenschaftsorganisation Zwischen der Universität Tübingen und der RIKEN-Wissenschaftsorganisation, einem japanischen Forschungsverbund vergle
Geschichte & Archeologie - Medien - 18.05.2011
Die Kirchen und das Dritte Reich?
Gesundheit - Pädagogik - 13.05.2011
Kindlicher Spracherwerb und Sprachverarbeitung
Wirtschaft - Pädagogik - 13.05.2011
Stiftung Weltethos errichtet Weltethos-Institut an der Universität Tübingen
Wirtschaft - Biowissenschaften - 12.05.2011
Wirtschaft - Pädagogik - 11.05.2011
Ehrensenatorenwürde für Thomas Lindner, Chef des Unternehmens Groz-Beckert in Albstadt
Geschichte & Archeologie - 10.05.2011
Hoher Besuch aus dem Oman an der Universität Tübingen
Psychologie - Biowissenschaften - 10.05.2011
Museum der Universität Tübingen öffnet am Internationalen Museumstag Türen
Geschichte & Archeologie - Gesundheit - 09.05.2011
Zigeunerforschung , Kriminalbiologie und Zwangssterilisation von Zigeunern an der Universität Tübingen
Neuer Bericht des Arbeitskreises 'Universität Tübingen im Nationalsozialismus' Der Arbeitskreis 'Universität Tübingen im Nationalsozialismus' hat sich als interdisziplinäre Forschergruppe dem Themenfeld der ,Zigeunerforschung', der ,Kriminalbiologie?
Umwelt - Wirtschaft - 06.05.2011
Den gesellschaftlichen Wandel mitgestalten: Ökosoziale Studientage an der Universität Tübingen
Biowissenschaften - 05.05.2011
Veredelung von Apfelbäumen
Gesundheit - Sozialwissenschaften - 04.05.2011
Aktuelle Trends in der Medizinerausbildung: Shaping Diamonds: From Bench to Bedside?
Geschichte & Archeologie - Pädagogik - 03.05.2011
Aufbau des Zentrums für Islamische Theologie an der Universität Tübingen schreitet voran
Pädagogik - Veranstaltung - 29.04.2011
Das Auto der Zukunft in der 10. Tübinger Kinder-Uni
Linguistik & Literatur - 29.04.2011
The Literary Market in the UK?
Biowissenschaften - 28.04.2011

Linguistik & Literatur - Medien - 27.04.2011
Fremde Fracht 8. Baden-Württembergische Übersetzertage vom 4. bis 8. Mai 2011 in Tübingen
Kooperationsprojekt von Universität und Universitätsstadt Tübingen 'Fremde Fracht' lautet das Thema der 8.
Gesundheit - Biowissenschaften - 27.04.2011
Universität Tübingen wird Partnerstandort bei zwei weiteren Zentren der Gesundheitsforschung
Ausbau von Infektiologie und Onkologie für bundesweite Vernetzung In einem vom Bundesministerium für Bildung und Forschung (BMBF) ausgeschriebenen Wettbewerb für Partnerstandorte der Gesundheitszentr
Wirtschaft - Biowissenschaften - 26.04.2011
Mit Immuntherapie Krebszellen bekämpfen
Linguistik & Literatur - Geschichte & Archeologie - 26.04.2011
Miteinander voneinander lernen - Japan-Tage an der Universität Tübingen
Linguistik & Literatur - Interdisziplinär / alle Kategorien - 21.04.2011
Migration der Künste Künste der Migration?
Wirtschaft - Informatik - 21.04.2011
Existenzgründungs-Förderung für interaktive Telekonferenz-Lösung
Biowissenschaften - Gesundheit - 19.04.2011
Das Exzellenzcluster CIN der Universität Tübingen ist jetzt komplett aufgestellt
Zwischenbilanz der neurowissenschaftlichen Spitzenforschung in Tübingen Vor dreieinhalb Jahren wurden im Rahmen der Exzellenzinitiative des Bundes und der Länder 30 Mio.
Linguistik & Literatur - Geschichte & Archeologie - 14.04.2011
Das erste Literaturarchiv von Hindi-Zeitschriften online
Die einzigartige Sammlung der Universität Tübingen enthält etwa 4500 Literaturzeitschriften in Hindi Die Abteilung Indologie und Vergleichende Religionswissenschaft des Asien-Orient-Instituts der Universität Tübingen verfügt über eine einzigartige Sammlung an Literaturzeitschriften.
Medien - Sozialwissenschaften - 13.04.2011
Der Skandal und die Medien
Ringvorlesung der Medienwissenschaft der Universität Tübingen mit prominenten Gästen Welche Ereignisse lösen öffentliche Empörung aus, welche nicht?
Wirtschaft - 13.04.2011
Uni Tübingen vergibt jetzt Deutschlandstipendien?
Geschichte & Archeologie - Gesundheit - 12.04.2011
Forschungspreis für die historische Aufarbeitung der Rolle der Ärzteschaft in der NS-Zeit an Tübinger Doktorandin
Gesundheit - 11.04.2011
Patientennah und laborunabhängig: Geräteausstellung zur Akut-Diagnostik an der Universität Tübingen
Patientennahe Diagnostik bekommt im Rettungswagen, in der Notfallaufnahme und auf Krankenhausstationen eine immer größere Bedeutung.
Sport - 11.04.2011
Fleecejacken und Poloshirts mit Uni-Logo
Universität Tübingen präsentiert erstmals eigene Sportkollektion Vor dem Hauptgebäude der Universität Tübingen, der Neuen Aula, haben am heutigen 11. April zum Start der Vorlesungszeit des Som
Pädagogik - Veranstaltung - 08.04.2011
Zum 10. Mal: die Tübinger Kinder-Uni
Recht - 08.04.2011
Betriebsübergang ein unkalkulierbares Risiko?
6. Tübinger Arbeitsrechtstag am 15. April 2011 Der 6. Tübinger Arbeitsrechtstag am 15. April 2011 geht unter dem Titel 'Betriebsübergang ' ein unkalkulierbares Risiko?? aktuellen Rechts- und Gestaltungsfragen zu § 613a BGB nach.
Geschichte & Archeologie - Pädagogik - 07.04.2011
Studium Generale der Universität Tübingen im Sommersemester 2011
Physik - 06.04.2011
Der Himmel. Wunschbild und Weltverständnis
Neue Ausstellung des Museums der Universität Tübingen MUT auf dem Schloss Das Museum der Universität Tübingen MUT zeigt vom 15. April bis zum 31. Juli 2011 eine Ausstellung zum Thema 'Himmel' im Schloss Hohentübingen.
Linguistik & Literatur - 06.04.2011
Universität Tübingen erhält für Alexander von Humboldt-Professur 5 Millionen Euro
Gesundheit - Informatik - 05.04.2011
Rechenzentrum erhält modernen Serverneubau
Universität Tübingen stärkt IT-Infrastruktur Forschung und Lehre auf führendem Niveau sind nur möglich, wenn sie durch eine leistungsfähige IT-Infrastruktur mit stabilen und vielfältigen Diensten unt
Geschichte & Archeologie - 04.04.2011
Benachteiligung durch Sicherheitstechnologien Wenn der Urinbeutel zum Sicherheitsrisiko wird
Neues Forschungsprojekt KRETA am Internationalen Zentrum für Ethik in den Wissenschaften (IZEW) der Universität Tübingen gestartet Wir alle wollen ein Mehr an Sicherheit, aber welchen Preis sind wir bereit dafür zu zahlen?
Biowissenschaften - 31.03.2011

Geschichte & Archeologie - 30.03.2011
Exponat Inszenierung Authentizität. Leitbegriffe des Museums
Linguistik & Literatur - 22.03.2011
Preisträger des Würth-Literaturpreises 2011 stehen fest
Physik - 16.03.2011
Nachwuchs-Teilchenforscher in Physiklabors
Kepler Center für Astro- und Teilchen-Physik der Universität Tübingen empfängt 25 Schülerinnen und Schüler Raus aus dem Klassenzimmer und rein in die Forschung: Im Rahmen der Internationalen Schülerf
Chemie - Physik - 15.03.2011
Tübinger Nachwuchsgruppenleiterin in der Chemie erhält Jahrespreis der ADUC
Biowissenschaften - 10.03.2011
Flor-a-rt Mischtechniken und Aquarelle?
Pädagogik - Medien - 09.03.2011
Gemeinsam promovieren: Zusammenarbeit der Universität Tübingen mit Hochschulen
Wissenschaftsministerium fördert drei Promotionskollegs der Universität Tübingen, Landesgraduiertenförderung ermöglicht vier 'Twinning Projects' Promotionskollegs und 'Twinning Projects' machen es möglich, dass Absolventen von Universitäten und Hochschulen gemeinsam promovieren.
Biowissenschaften - 02.03.2011
Rückblick auf 10.000 Jahre erfolgreiche Pflanzenzüchtung?
Pädagogik - Interdisziplinär / alle Kategorien - 02.03.2011
Zukunftskonzept, zwei Graduiertenschulen und ein Cluster
Universität Tübingen mit vier Projekten in der Endrunde der Exzellenzinitiative In der 2. Runde der Exzellenzinitiative des Bundes und der Länder kommt die Universität Tübingen mit ihrem Zukunftskonzept, zwei Graduiertenschulen und einem Exzellenzcluster in die Endrunde.
Gesundheit - 28.02.2011
Verleihung der ersten Tübingen Distinguished Guest Professorship?
- 28.02.2011
Europäisches Taiwanzentrum an der Universität Tübingen wird weiter gefördert
Chemie - Medien - 28.02.2011
Neu berufene Professoren der Universität Tübingen werden mit Videobeiträgen vorgestellt
Medien - 28.02.2011
Neue Ausgabe von Uni Tübingen aktuell ist erschienen
Wirtschaft - 25.02.2011
Preiskampf der Wirtschaftsprüfer
Studie der Universität Tübingen zeigt: Marktmacht der großen Wirtschaftsprüfungsgesellschaften nimmt zu Seit nunmehr achtzig Jahren schreibt das Aktienrecht vor, dass Aktiengesellschaften ihre Abschlüsse prüfen lassen müssen.
Campus - UNI-LEIPZIG - Heute
Höchster deutscher Forschungsförderpreis an Johannes Krause und Christian Doeller verliehen
Höchster deutscher Forschungsförderpreis an Johannes Krause und Christian Doeller verliehen

Psychologie - 18.3
Psychische Belastung bei Kindern und Jugendlichen steigt erstmals nach Pandemie wieder an
Psychische Belastung bei Kindern und Jugendlichen steigt erstmals nach Pandemie wieder an
Medien - 18.3
Offener Brief des Leipzig Science Network zum 5. Erweiterungsbau der Deutschen Nationalbibliothek in
Offener Brief des Leipzig Science Network zum 5. Erweiterungsbau der Deutschen Nationalbibliothek in

Campus - UNI-LEIPZIG - 17.3
Innovative Lehre in der Archäologie: Wissenstransfer durch eigene Podcasts
Innovative Lehre in der Archäologie: Wissenstransfer durch eigene Podcasts










